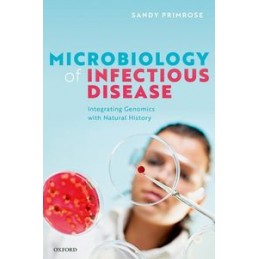
Microbiology of Infectious...

- There are no more items in your cart
- Shipping
- Total 0.00 zł
- Medicine - polish books
- Anatomy
- Anestezjology & intensive care
- Chemistry & biochemistry
- Surgery
- Infectious diseases
- Dermatology and cosmetology
- Laboratory medicine
- Diagnostic imaging
- For candidates for medical studies
- Epidemiology and public health
- Pharmacy
- Pharmacology
- Physiology
- Genetics
- Gynecology and obstetrics
- Histology & embryology
- Immunology
- Internal medicine
- Foreign Languages
- L-DEK exams
- LEK exams
- Naturopathy
- Paliative medicine
- Occupational medicine
- Emergency medicine
- Family practice
- Forensics
- Sports medicine
- Microbiology
- Related sciences
- Neurology
- Ophtalmology
- Oncology
- Healthcare management
- Otorhinolaryngology
- Pathophysiology
- Pathology
- Pediatrics
- Nursing
- Psychiatry
- Health psychology
- Rehabilitation and physiotherapy
- Sexology
- Dentistry
- Veterinary
- Human nutrition
- Health
- Allergies
- Medical tests
- Pain
- Abdominal diseases
- Woman's health
- Man's health
- Neurological diseases
- Diseases of the eyes, ears
- Lung diseases
- Mental disorders
- Heart and vascular diseases
- Pregnancy and childbirth
- Diets
- Child
- Hormones
- Bones, joints, muscles
- Medicines
- Massages, Gymnastics, Rehabilitation
- natural medicine
- Medycyna niekonwencjonalna
- Hypertension, diabetes, hypercholesterolemia
- Neurobiologia
- Niepełnosprawność
- Cancers
- Guides, encyclopedias
- Seks
- sleep
- Skóra - choroby, pielęgnacja
- Sprawność fizyczna
- Addiction
- Embarrassing problems
- Teeth
- Pets
- Psychology
- Gerontology
- Kinesiology
- Methodology and statistics
- Neuropsychology
- NLP
- Parapsychology
- Education
- Psychological guides
- Social work
- Working with groups
- Psychoanalysis
- Psychology of emotions and motivation
- Clinical psychology
- Consumer psychology
- General psychology
- Psychology of organization and management
- Psychology of personality and individual differences
- Cognitive psychology
- Relationship psychology
- Family psychology
- Developmental psychology
- Forensic and penitentiary psychology
- Social psychology
- Educational psychology
- Psychology - other
- Psychopathology
- Psychotherapy
- Sociology
- Addiction
- Medicine - english books
- Allied Health Services All
- Allied Sciences
- Anatomy
- Anesthesiology
- Audiology & Speech Pathology
- Biochemistry
- Biostatistics
- Clinical Medicine
- Clinical Psychology
- Complementary Therapies
- Cosmetology
- Dentistry
- Dermatology
- Diagnostic Imaging
- Dictionaries & Terminology
- Diet Therapy
- Drug Guides
- Embryology
- Emergency Medicine
- Epidemiology
- Exams
- Family Practice
- Forensic Medicine
- Genetics
- Gynecology
- Health & Fitness
- Health Information Management
- Histology
- Human Nutrition
- Immunology
- Infectious Diseases
- Intensive Care
- Internal Medicine
- Laboratory Medicine
- Medical Administration
- Microbiology
- Neurology
- Nursing
- Nursing / Anesthesia
- Nursing / Assessment & Diagnosis
- Nursing / Critical & Intensive Care
- Nursing / Emergency
- Nursing / Fundamentals & Skills
- Nursing / Gerontology
- Nursing / Home & Community Care
- Nursing / Issues
- Nursing / LPN & LVN
- Nursing / Management & Leadership
- Nursing / Maternity, Perinatal, Women's Health
- Nursing / Medical & Surgical
- Nursing / Nurse & Patient
- Nursing / Nutrition
- Nursing / Oncology & Cancer
- Nursing / Pediatric & Neonatal
- Nursing / Pharmacology
- Nursing / Psychiatric
- Nursing / Reference
- Nursing / Research & Theory
- Nursing / Test Preparation & Review
- Nursing Home Care
- Occupational Health
- Oncology
- Ophthalmology
- Otorhinolaryngology
- Paliative medicine
- Pathology
- Pathophysiology
- Pediatrics
- Perinatology and Neonatology
- Pharmacology
- Pharmacy
- Physiology
- Podiatry
- Preventive Medicine
- Psychiatry
- Radiological and Ultrasound Technology
- Radiology
- Rehabilitation
- Research
- Sexuology
- Sleep Medicine
- Sports Medicine
- Surgery
- Veterinary
- New releases
- Coming soon
List of products by brand OUP Oxford
Reference: 93484
So you want to be a brain surgeon?
Author: Lydia Spurr
The essential guide to medical careers
Reference: 93518
The EHRA Book of Pacemaker, ICD and CRT Troubleshooting Vol. 2
Author: Haran Burri
Case-based learning with multiple choice questions
Reference: 93499
Microbiology of Infectious Disease
Author: Sandy R. Primrose
Integrating Genomics with Natural History
Reference: 93262
Research Methods Using R
Author: Daniel H. Baker
Advanced Data Analysis in the Behavioural and Biological Sciences
Reference: 93495
Middle English Medical Recipes and Literary Play, 1375-1500
Author: Hannah Bower
Reference: 93385
Music Therapy in Mental Health for Illness Management and Recovery
Author: Michael J. Silverman
Reference: 93388
A Geography of Infection
Author: Peter Haggett
Spatial Processes and Patterns in Epidemics and Pandemics
Reference: 93491
Can precision medicine be personal Can personalized medicine be precise?
Author: Y. Michael Barilan